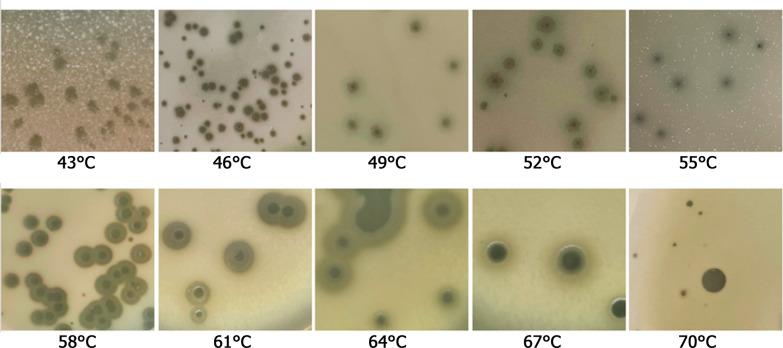
https://cdn.ncbi.nlm.nih.gov/pmc/blobs/943b/10131341/04d85d883751/12934_2023_2086_Fig3_HTML.jpg

一种新型耐热 TP-84 胶囊解聚酶:一种快速处理噬菌体表达蛋白的聚乙烯亚胺的方法。
A novel thermostable TP-84 capsule depolymerase: a method for rapid polyethyleneimine processing of a bacteriophage-expressed proteins.
机构信息
Faculty of Health and Life Sciences, Division of Biochemistry, Gdansk University of Physical Education and Sport, Gorskiego 1, 80-336, Gdansk, Poland.
Faculty of Chemistry, Department of Molecular Biotechnology, University of Gdansk, Wita Stwosza 63, 80-308, Gdansk, Poland.
出版信息
Microb Cell Fact. 2023 Apr 25;22(1):80. doi: 10.1186/s12934-023-02086-2.
BACKGROUND
In spite of the fact that recombinant enzymes are preferably biotechnologically obtained using recombinant clones, the purification of proteins from native microorganisms, including those encoded by bacteriophages, continues. The native bacteriophage protein isolation is often troubled by large volumes of the infected bacterial cell lysates needed to be processed, which is highly undesired in scaled-up industrial processing. A well-known ammonium sulphate fractionation is often a method of choice during purification of the native bacteriophage protein. However, this method is time-consuming and cumbersome, and requires large amounts of the relatively expensive reagent. Thus, other effective and inexpensive methods of reversible protein precipitation are highly desirable. We have previously characterized thermophilic TP-84 bacteriophage, defined a new genus TP84virus within Siphoviridae family, conducted the TP-84 genome annotation and proteomic analysis. The longest Open Reading Frame (ORF) identified in the genome is TP84_26. We have previously annotated this ORF as a hydrolytic enzyme depolymerizing the thick polysaccharides host's capsule.
RESULTS
The TP84_26 'capsule depolymerase' (depolymerase) is a large, 112 kDa protein, biosynthesized by the infected Geobacillus stearothermophilus 10 (G. stearothermophilus 10) cells. The TP84_26 protein biosynthesis was confirmed by three approaches: (i) purification of the protein of the expected size; (ii) mass spectrometry (LC-MS) analysis and (iii) detection of the enzymatic activity toward G. stearothermophilus polysaccharide capsules. Streptomycin-resistant mutant of the host was generated and microbiological aspects of both the TP-84 and G. stearothermophilus 10 were determined. A new variant of polyethyleneimine (PEI)-mediated purification method was developed, using the novel TP-84 depolymerase as a model. The enzyme was characterized. Three depolymerase forms were detected: soluble, unbound proteins in the bacteriophage/cells lysate and another integrated into the TP-84 virion.
CONCLUSIONS
The novel TP-84 depolymerase was purified and characterized. The enzyme exists in three forms. The soluble, unbound forms are probably responsible for the weakening of the capsules of the uninfected bacterial cells. The form integrated into virion particles may generate a local passage for the invading TP-84. The developed PEI purification method appears well suited for the scaled-up or industrial production of bacteriophage proteins.
背景
尽管重组酶最好通过使用重组克隆的生物技术获得,但仍在继续从天然微生物中纯化蛋白质,包括那些由噬菌体编码的蛋白质。从天然噬菌体中分离蛋白质通常会受到需要处理的大量感染细菌细胞裂解物的困扰,这在规模化工业处理中是非常不理想的。硫酸铵分级分离通常是纯化天然噬菌体蛋白质的首选方法。然而,这种方法耗时且繁琐,并且需要大量相对昂贵的试剂。因此,非常需要其他有效且廉价的可逆蛋白质沉淀方法。我们之前已经对嗜热 TP-84 噬菌体进行了表征,在 Siphoviridae 科内定义了一个新的属 TP84virus,并进行了 TP-84 基因组注释和蛋白质组学分析。在基因组中鉴定出的最长开放阅读框 (ORF) 是 TP84_26。我们之前将该 ORF 注释为一种水解酶,可分解宿主胶囊的厚多糖。
结果
TP84_26“胶囊解聚酶”(解聚酶)是一种大型 112 kDa 蛋白质,由感染的嗜热脂肪地芽孢杆菌 10(G. stearothermophilus 10)细胞生物合成。通过三种方法证实了 TP84_26 蛋白的生物合成:(i)纯化预期大小的蛋白质;(ii)质谱分析(LC-MS)和(iii)检测对嗜热脂肪地芽孢杆菌多糖胶囊的酶活性。生成了宿主的链霉素抗性突变体,并确定了 TP-84 和 G. stearothermophilus 10 的微生物学方面。开发了一种新的聚亚乙基亚胺(PEI)介导的纯化方法,使用新型 TP-84 解聚酶作为模型。对该酶进行了表征。检测到三种解聚酶形式:噬菌体/细胞裂解物中未结合的可溶性蛋白质和另一种整合到 TP-84 病毒粒子中的蛋白质。
结论
新型 TP-84 解聚酶已被纯化和表征。该酶有三种形式。可溶性、未结合的形式可能负责削弱未感染细菌细胞的胶囊。整合到病毒粒子中的形式可能为入侵的 TP-84 生成局部通道。开发的 PEI 纯化方法似乎非常适合噬菌体蛋白的规模化或工业化生产。